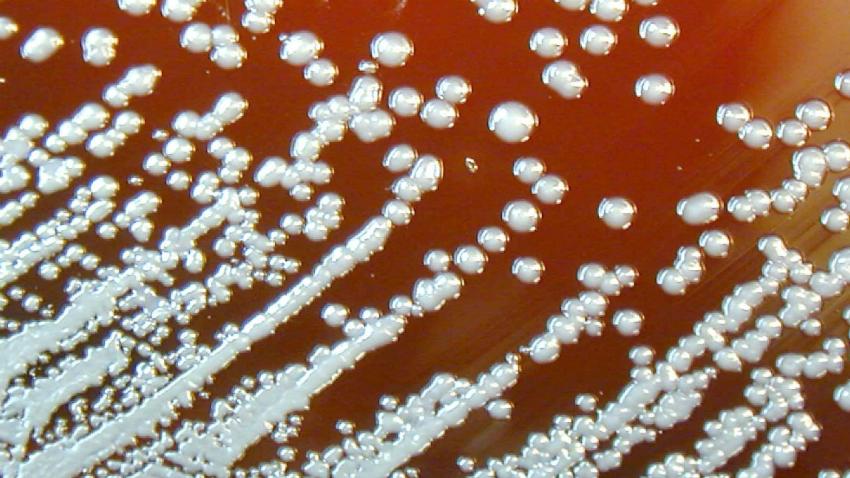

ECCMID
@eccmid
European Congress of Clinical Microbiology and Infectious Diseases organised by ESCMID. #ECCMID2016
ID: 107347845
http://www.eccmid.org 22-01-2010 08:03:34
1,1K Tweet
5,5K Followers
881 Following


My best RTs this week came from: Astronomía + Ciencia microBIO EYEonHATE2Goyim @ilariaguarda #thankSAll Who were yours? sumall.com/thankyou















My best RTs this week came from: microBIO Dr Mel Thomson ICU Management Pam Das 💙👊🏾⚖️ #thankSAll Who were yours? sumall.com/thankyou